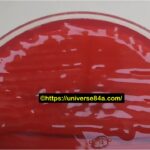
Enterobacter cloacae: Introduction, Morphology, Pathogenicity, Lab Diagnosis, Treatment, Prevention, and Keynotes

Tag: Carbapenems
Enterobacter cloacae: Introduction, Morphology, Pathogenicity, Lab Diagnosis, Treatment, Prevention, and Keynotes
 Introduction Enterobacter cloacae is a Gram-negative, rod-shaped bacterium belonging to...
Introduction Enterobacter cloacae is a Gram-negative, rod-shaped bacterium belonging to...
Introduction Enterobacter cloacae is a Gram-negative, rod-shaped bacterium belonging to...
Introduction Enterobacter cloacae is a Gram-negative, rod-shaped bacterium belonging to...